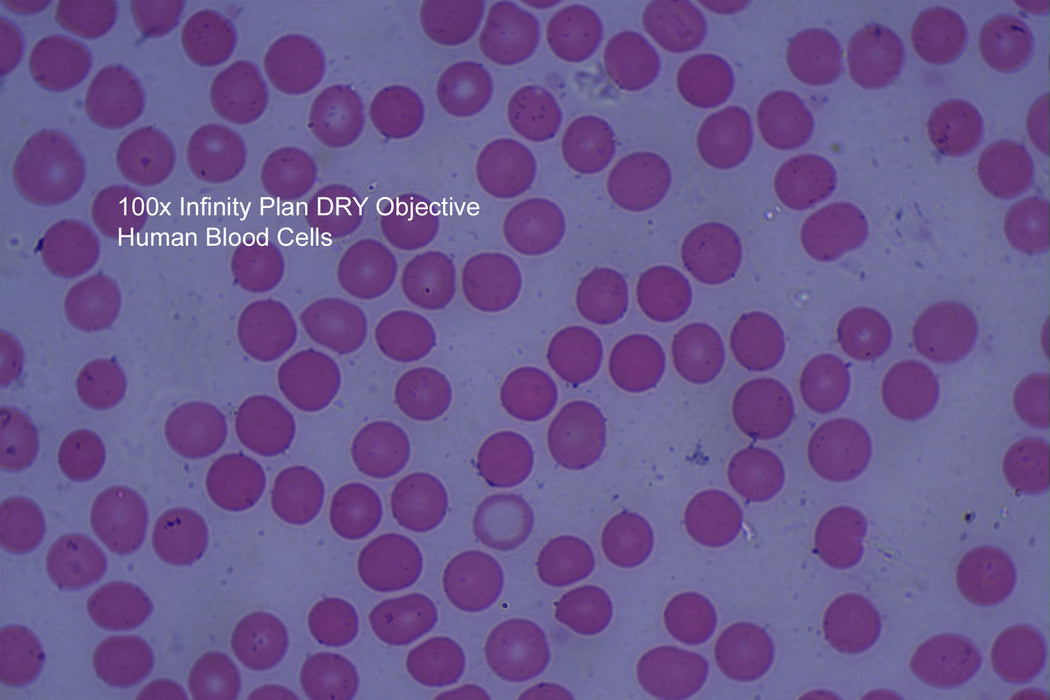

100X Infinity Plan DRY Objective - NEVER use oil again
by Optico
Original price
$595.00
-
Original price
$595.00
Original price
$595.00
$595.00
-
$595.00
Current price
$595.00
Tired of cleaning oil off your 100x objective?
The new 100x INFINITY PLAN objective will make your work procedure faster and more productive. NEVER use oil again.
- No more cleaning oil from the 100x objective again
- No more contamination of the 40x objective with oil
- No need to buy immersion oil ever again
- No more wiping oil off a slide and cleaning again
- Less frequent servicing of your microscope
- Increased work efficiency faster scanning of slides
- Cleaner working environment
- Save time and money
The frustration we hear from vets many times is the blocking up of their 100x OIL immersion lens with old oil and the contamination of the 40x dry objective. After an extended period of time, if the oil isnt cleaned off the lens after every use, the immersion oil can penetrate deep into the lens and require expert cleaning or, in some cases, the replacement of the objective completely. Now your frustration is over; try our new 100x dry objective.
Fits common size (DIN/JIS international standard) Compound Biological Microscopes
- 100X DRY Infinity Plan Objective
- 1000X Magnification Power (With standard 10x eyepieces)
- 100X/0.9
- Standard RMS thread
- 5-Year Warranty